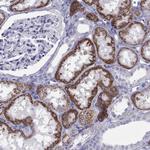
TRPM3 Antibody in Immunohistochemistry (Paraffin) (IHC (P))

Search
Invitrogen
TRPM3 Polyclonal Antibody
{{$productOrderCtrl.translations['antibody.pdp.commerceCard.promotion.promotions']}}
{{$productOrderCtrl.translations['antibody.pdp.commerceCard.promotion.viewpromo']}}
{{$productOrderCtrl.translations['antibody.pdp.commerceCard.promotion.promocode']}}: {{promo.promoCode}} {{promo.promoTitle}} {{promo.promoDescription}}. {{$productOrderCtrl.translations['antibody.pdp.commerceCard.promotion.learnmore']}}
产品信息
PA5-139988
种属反应
宿主/亚型
分类
类型
抗原
偶联物
形式
浓度
规格
纯化类型
保存液
内含物
保存条件
运输条件
RRID
产品详细信息
Gently mix before use. Optimal concentrations and conditions for each application should be determined by the user.
Immunogen sequence: VDIRLAQLED LIGRMATALE RLTGLERAES NKIRSRTSSD CTDAAYIVRQ SSFNSQEGNT FKLQ
Highest antigen sequence indentity to the following orthologs: Rat - 100%, Mouse - 100%.
靶标信息
The product of this gene belongs to the family of transient receptor potential (TRP) channels. TRP channels are cation-selective channels important for cellular calcium signaling and homeostasis. The protein encoded by this gene mediates calcium entry, and this entry is potentiated by calcium store depletion. Alternatively spliced transcript variants encoding different isoforms have been identified.
仅用于科研。不用于诊断过程。未经明确授权不得转售。
篇参考文献 (0)
生物信息学
蛋白别名: KI; Long transient receptor potential channel 3; LTrpC-3; Melastatin-2; MLSN2; Transient receptor potential cation channel subfamily M member 3; unnamed protein product
基因别名: CTRCT50; GON-2; KIAA1616; LTRPC3; MLSN2; NEDFSS; TRPM3
UniProt ID: (Human) Q9HCF6
Entrez Gene ID: (Human) 80036